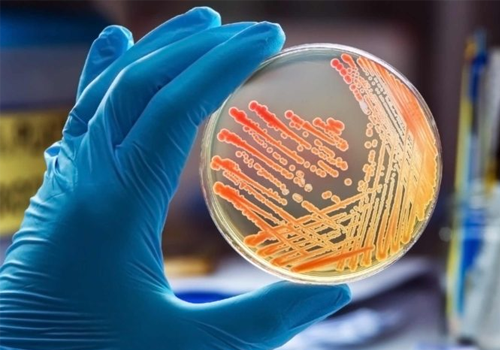

Blood Tests

State of Art Facility
Offer the latest in laboratory equipment and technology. Our state-of-the-art equipment is designed to give you the most accurate and precise results in a timely manner.
Latest Equipment
We are committed to providing our patients with the best possible testing experience, which is why we have invested in a state-of-the-art facility
Qualified Staff
SPANDAN PATHOLOGY LAB is dedicated to providing the highest quality of clinical laboratory testing services in the industry.
Helpful Test Tips
It is a long established fact that a reader will be distracted by the readable content.

About Us - Spandan Pathology Lab
Welcome to Spandan Pathology Lab, a trusted name in diagnostic testing committed to providing high-quality, accurate, and timely medical testing services. Our lab has been serving the community with precision, care, and the latest advancements in pathology for years. We understand that accurate diagnostics are crucial for effective treatment, and that is why we prioritize reliability and excellence in every test we perform.
Our Mission:
At Spandan Pathology Lab, our mission is to deliver trustworthy diagnostic solutions that empower healthcare providers and patients in their decision-making. We strive to foster a healthier community by offering comprehensive pathology services with a focus on accuracy, speed, and personalized care.
Our Services:
We offer a wide range of diagnostic services, including but not limited to:-
-
Urine Tests
-
Biopsy & Cytology
-
Microbiology
What We Offer
It is a long established fact that a reader will be distracted by the readable content of a page when looking at its layout.


Clinical Pathology
The Department of Clinical Pathology at Spandan Pathology Lab Laboratory...

Biochemical And Immunoassay
Biochemistry is the study of chemical and biochemical components in the body...

Serology
When people are exposed to viruses or bacteria their body’s immune system generates particular...

Cytopathology
At Spandan Pathology Lab Laboratory in Pune, Cytopathology is a state-of-the-art facility
Microbiology
Spandan Pathology Lab Laboratory in Pune provides complete clinical services for the diagnosis,

Testing By Our Expert Laboratory Scientists
A laboratory (lab) test checks a sample of your blood, urine (pee), or other body fluid or tissue to learn about your health. The sample is sent to a lab where health care professionals test it to see if it contains certain substances and, if so, how much.
Sample Preparation 85%
Environmental Testing 65%
Advanced Microscopy 75%
Pasante Results
+ Our Equipments
+ Active Experts
+ Awards Winning
General frequently asked questions
It is a collection of common questions and answers not specific to a product, feature, or service. They usually cover payment policies, how to contact customer support, and refund policies.
It is a long established fact that a reader will be distracted by the readable content of a page when looking at its layout.
Ask Question
We Are New Standards in Laboratory & Research
Research carried out in a laboratory for testing chemical substances, growing tissues in cultures, or performing microbiological, biochemical, hematological, microscopical, immunological, parasitological tests, etc.
-
Free Home Sampling
-
Patient Support
-
Latest Equipment
-
High End Technology
-
Qualified Staff
-
Research Center
We Offer Quality Service
We'll Ensure You Always Get The Best Results
It is a long established fact that a reader will be distracted by the readable content
of a page when looking at its layout.
What Client Say's
It is a long established fact that a reader will be distracted by the readable content of a page when looking at its layout.






